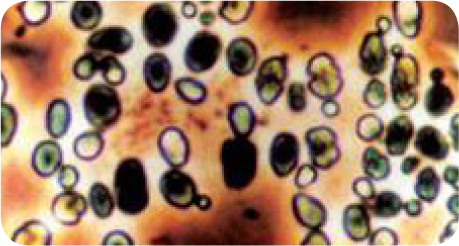
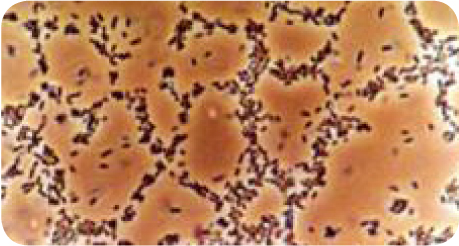

|
| ³ó¾÷, Ãà»ê, ¼ö»ê ´Ù¿ëµµ Ȱ¿ëÀÌ °¡´ÉÇÑ EM ¹è¾ç±â |
|
| ¡ß Model. MTEB 700 [ƯÇã 0423253] |
|
¡ß Model. MTE 700 |
 |
|
 |
|
|
|
|
|
EM(Effective Microorganisms)Àº À¯¿ë ¹Ì»ý¹°±ºÀÇ ¾àÀڷμ ±¤ÇÕ¼º±Õ, À¯»ê±Õ, È¿¸ð±ÕÀ» ÁÖ±ÕÀ¸·Î ÇÏ¿© Àΰ£°ú ȯ°æ¿¡ À¯ÀÍÇÑ ¹Ì»ý¹°À» Á¶ÇÕ, ¹è¾çÇÑ ¹Ì»ý¹° º¹ÇÕü¸¦ ¸»ÇÕ´Ï´Ù. EMÀº ¹Ì»ý¹° ±Õµé °£ÀÇ º¹ÀâÇÑ °øÁ¸°ø»ý °ü°è¸¦ ÅëÇØ ¹ßÈ¿»ý¼º¹°ÀÎ Ç×»êȹ°ÁúÀ» ¸¸µé¾î³»°Ô µÇ´Âµ¥, ÀÌ Ç×»êȹ°ÁúÀº ºÎÆÐ ¹× ¿À¿°µÇ¾î °¡´Â ÀÚ¿¬À» ¼Ò»ý½ÃŰ°í º´µé¾î°¡´Â ȯ°æÀ» Ä¡À¯ÇÏ´Â ´É·ÂÀ» ¹ßÈÖÇÕ´Ï´Ù.
|
|
|
|
|
|
|
|
|
 |
| È¿¸ð±Õ |
|
À¯»ê±Õ |
|
±¤ÇÕ¼º ¼¼±Õ |
¤ý¹ßÈ¿ÇÕ¼ºÀ» ÇÏ´Â ±Õ(»§, ¸ÆÁÖ, ¿ÍÀÎ µî ¾ËÄÚ¿Ã ÇÕ¼º¿¡ ºüÁöÁö ¾Ê´Â ¹Ì»ý¹°
¤ý¾Æ¹Ì³ë»ê°ú ºñŸ¹ÎÀ» ´ë·® ÇÕ¼ºÇÏ´Â ´É·Â
¤ýÅä¾ç ¼Ó¿¡¼´Â ÁÁÀº ¹Ì»ý¹°À» »ý»êÇϱâ À§ÇÑ ¸ÔÀ̰¡ µÊ
|
|
¤ý¿ä±¸¸£Æ®, Ä¡Áî Á¦Á¶¿¡ »ç¿ëµÇ´Â ¹Ì»ý¹°
¤ýºÎÆÐÇϱ⠽¬¿î ¹°ÁúÀ» Àå±â°£ º¸Á¸ÇÒ ¼ö ÀÖÀ½
¤ýEM¿¡¼´Â À¯±â¹°À» ÃÖÃÊ·Î ¹ßÈ¿, ºÐÇØ½ÃÅ´
|
|
¤ý°í¼¼±ÕÀÇ ÀÏÁ¾
¤ý½Äǰ°¡°ø¿¡¼´Â Ä¡Áî¿Í ¾îÀå¿¡ ÀϺΠÁ¸Àç
¤ýÈ¿¸ð, À¯»ê±Õ°ú °øÁ¸ÇÔÀ¸·Î¼ ºü¸¥ ÇÕ¼º, ¹ßÈ¿·Â ¹ßÈÖ
|
|
|
|
|
|
¤ý°¡ÃàÀÇ ¼ºÀå°È ¹× ǰÁú°³¼±
¤ýȲ»êÈ È¿°ú
|
|
¤ýÄÝ·¹½ºÅ×·Ñ ÇÔ·® °¨¼ÒÈ¿°ú
¤ýÃàºÐ ¾ÇÃëÁ¦°Å È¿°ú
|
|
|
|
|
|
|
|
|
¤ýsts 304 3.0 ³»±¸¼º °È
¤ý³»¡¤¿ÜºÎ ¹öÇÎ ¿¬¸¶·Î ¿À¿° ÃÖ¼ÒÈ (¼±ÅÃ)
¤ýµðÁöÅйæ½Ä ÄÜÆ®·Ñ·¯
¤ýÆø±â °¡¿Â ¼øÈ¯ ±³¹Ý Àü°øÁ¤ ÀÚµ¿È½ÇÇö
¤ýÁÖÈ÷ÅÍ °£Á¢°¡¿Â¹æ½Ä(ƯÇã), ¹Ì»ý¹° »ç¸ê ÃÖ¼ÒÈ
|
|
¤ýÀúºñ¿ë °íÈ¿À² ¹Ì»ý¹° ¹è¾ç
¤ýº¸Á¶È÷ÅÍ ºÎÂøÀ¸·Î »ì±Õ °¡´É
¤ýÀü¸é ¸ÇȦ ºÎÂøÀ¸·Î û¼Ò ¹× »çÈİü¸® ¿ëÀÌ
¤ý±³¹Ý±â ¹× ¹æÇØÆÇ ºÎÂøÀ¸·Î ±³¹Ý ¿ëÀÌ
¤ý¼øÈ¯ÆßÇÁ ÀåÂøÀ¸·Î ¿ø°Å¸® ÀÌ¼Û °¡´É
|
|
|
|
|
|
 µðÁöÅÐÄÁÆ®·Ñ ¹Ú½º |
|
 ±âÆ÷±â |
|
 Åõ±¤±â |
|
 ¹èÁöÅõÀÔ±¸ |
|
 ±³¹ÝÀåÄ¡ |
|
|
 ¾Ð·ÂÁ¶ÀýÀåÄ¡ |
|
 ÁÖÈ÷ÅÍ / º¸Á¶È÷ÅÍ |
|
 ¼øÈ¯¤ýÀÌ¼Û ÆßÇÁ |
|
 ±³¹Ý³¯°³ |
|
|
|
|
|
|
| ±¸ºÐ |
MTEB700 |
MTE700 |
MTEB1300 |
MTE1300 |
| Total volume |
700L |
1,300L |
| Working volume |
500L |
1,000L |
| ¼¼ºÎ ±Ô°Ý |
STS304 3.0 ¨ª900 ¡¿ 1,000 |
STS304 3.0 ¨ª1,100 ¡¿ 1,220 |
| Leg |
STS304 3.0 ¨ª100 ¡¿ 600 |
STS304 3.0 ¨ª114 ¡¿ 600 |
| ±³¹Ý±â |
0.4Kw |
0.75Kw |
| °¡¿ÂÈ÷ÅÍ |
1.5Kw * 3(°£Á¢°¡¿Â) |
5Kw * 1(°£Á¢°¡¿Â) |
| °í¿ÂÈ÷ÅÍ |
2Kw * 2(Á÷Á¢°¡¿Â) |
5Kw * 1(Á÷Á¢°¡¿Â) |
| ±âÆ÷±â |
60L/min |
120L/min |
| Á¡°Ëâ |
Ø150 |
Ø150 * 2 |
| ·¥ÇÁ |
LED 12W |
LED 12W * 2 |
| ¸ÇȦ |
Ø390 ÇÚµé Á¶ÀÓ¹æ½Ä |
Ø490 ÇÚµé Á¶ÀÓ¹æ½Ä (Àü¸é)
Ø390 ÇÚµé Á¶ÀÓ¹æ½Ä (»óºÎ) |
| ÀÌ¼ÛÆßÇÁ |
PUS 604M |
PUS 604M |
| Buffing |
³»¿ÜºÎ ¹öÇÎ |
¡¿ |
³»¿ÜºÎ ¹öÇÎ |
¡¿ |
|
|
|
|
|
ģȯ°æ Ãà»ê ¾ÇÃëÀú°¨ (ÁÖ)¸Þ°¡ÅØ ¹Ì»ý¹° ¹è¾ç±â¿Í EMÀÌ µµ¿Íµå¸®°Ú½À´Ï´Ù.!!
|
|
|
| ÃàÁ¾ |
»ç¿ë¹æ¹ý |
±â´ëÈ¿°ú |
| ¼Ò |
Á¥¼Ò »ç¾ç »çÀÌŬ |
EM ó¸® |
¤ýÄÝ·¹½ºÅ×·Ñ 10% °¨¼Ò
¤ý¸¶ºí¸µ »óŰ¡ ÁÁ¾ÆÁü
¤ýÃàºÐ ¾ÇÃë °¨¼Ò
¤ýÀ°Áú °³¼± È¿°ú |
¹ø ½Ä |
Àϰü
À°¼º¿ì
±³¹Ì(¹ø½Ä)
ºÐ¸¸
Æ÷À°±â
³À¯±â
|
¤ýEM»ý±ÕÁ¦¸¦ 1µÎ´ç ¾à 30~50g ÷°¡
¤ýEMȰ¼º¾×À» 5~10ÀÏ¿¡ 1ȸ »ìÆ÷
¤ý¹°¿¡ 1,000¹è Èñ¼®ÇÑ EMȰ¼º¾×À» ±Þ¼ö
|
¤ýEM»ý±ÕÁ¦¸¦ 1µÎ´ç ¾à 30~100g ÷°¡
(¼ÒÀÇ ÅÐ °áÀ̳ª EM»çÀϸ®ÁöÀÇ »ç¿ë À¯¹« µîÀ¸·Î °¡°¨)
¤ýEMȰ¼º¾×À» 5~10ÀÏ¿¡ 1ȸ »ìÆ÷
¤ý¹°¿¡ 1,000¹è Èñ¼®ÇÑ EMȰ¼º¾×À» ±Þ¼ö
|
¤ýEM»ý±ÕÁ¦¸¦ 1µÎ´ç ¾à 30~100g ÷°¡
(¼ÒÀÇ ÅÐ °áÀ̳ª EM»çÀϸ®ÁöÀÇ »ç¿ë À¯¹« µîÀ¸·Î °¡°¨)
¤ýEMȰ¼º¾×À» 5~10ÀÏ¿¡ 1ȸ »ìÆ÷
¤ý¹°¿¡ 1,000¹è Èñ¼®ÇÑ EMȰ¼º¾×À» ±Þ¼ö
|
| ¾çµ· |
¾çµ· »çÀÌŬ |
EM ó¸® |
¤ý¼³»ç ¹ß»ýÀ² ÇöÀúÈ÷ °¨¼Ò
¤ýÃàºÐ ¾ÇÃë °¨¼Ò
¤ýÀÚµ· ¼ºÀå ÃËÁø È¿°ú
¤ýÀÚµ· Æó»çÀ² °¨¼Ò
¤ýÇ×»êÈÈ¿°ú 11% Áõ°¡
¤ýÇ״ܹéÁú º¯¼ºÈ¿°ú 25% Áõ°¡
¤ýÄÝ·¹½ºÅ×·Ñ 15% °¨¼Ò
|
| ÀÚµ· |
¤ýEM»ý±ÕÁ¦¸¦ »ç·á·®ÀÇ 1%(5Åæ ÅÊÅ©¿¡ 50kg) ÷°¡
¤ýEMȰ¼º¾×À» 5~10ÀÏ¿¡ 1ȸ »ìÆ÷
¤ýÀ½¼ö´Â EM¼¼¶ó¹Í ó¸®µÈ ±ú²ýÇÑ ¹°·Î ±Þ¿©
¤ýEMÈñ¼®¾× 1,000¹è Åõ¿©
|
| À°¼ºµ· |
¤ýEM»ý±ÕÁ¦¸¦ »ç·á·®ÀÇ 0.5~1%(5Åæ ÅÊÅ©¿¡ 25~50kg) ÷°¡
¤ýEMȰ¼º¾× »ìÆ÷ ¹× À½¼öó¸®
|
| ¸ðµ· |
¤ýEM»ý±ÕÁ¦¸¦ »ç·á·®ÀÇ 1%(5Åæ ÅÊÅ©¿¡ 50kg) ÷°¡
¤ýEMȰ¼º¾×À» 3~5ÀÏ¿¡ 1ȸ »ìÆ÷Çϰí Èñ¼®¾× 1,000¹è Åõ¿©
|
À°°è
&
»ê¶õ°è
À°°è
|
À°°è »çÀÌŬ |
EM ó¸® |
¤ý¾ÇÃë 60% ÀÌ»ó Àú°¨È¿°ú
¤ý»ýüÁß 10% ÀÌ»ó Áõ°¡
¤ýÇ¥ÇÇÁö¹æ 15% °¨¼Ò
¤ýÄÝ·¹½ºÅ×·Ñ 10% °¨¼Ò
¤ýÀ°Ã߽à ÁõüÀ²ÀÇ Áõ°¡
¤ýÆó»çÀ² °¨¼Ò
¤ý»ê¶õÀ² 5~6% Áõ°¡
¤ý»ê¶õµµÅ ¿¬Àå
¤ý³ë°è µÇ¾îµµ ³»ö ÁÁ°í, ³°¢ÀÌ ´Ü´ÜÇÔ
¤ýÃàºÐ ¾ÇÃë °¨¼Ò
|
ºÎÈ
»ýÀ°
»ê¶õ ¹× »ýÀ°
ÃâÇÏ
|
¤ýEM»ý±ÕÁ¦¸¦ »ç·á¿¡ 0.3~0.5% ÷°¡
¤ýEMȰ¼º¾× 300¹è Èñ¼®¾×À» 5~10ÀÏ¿¡ 1ȸ »ìÆ÷
¤ýEMȰ¼º¾×À» 1,000¹è Èñ¼®ÇÏ¿© À½¼ö¿¡ Åõ¿©
|
¤ýEM»ý±ÕÁ¦¸¦ »ç·á·®ÀÇ 0.5% ÷°¡
¤ýEMȰ¼º¾× 300¹è Èñ¼®¾×À» 5~10ÀÏ¿¡ 1ȸ »ìÆ÷
¤ýEMȰ¼º¾×À» 1,000¹è Èñ¼®ÇÏ¿© À½¼ö¿¡ Åõ¿©
|
|
|
 |